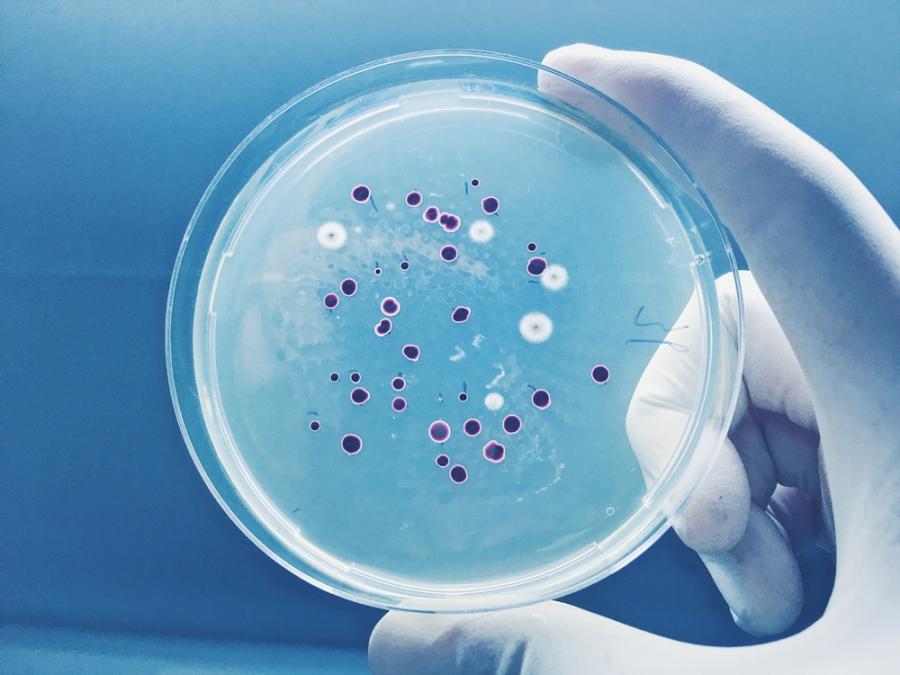

Как латентните бактериите преценяват кога да се върнат към живот
Когато са подложени на стресови условия и вече няма с какво да се хранят, някои бактерии преминават в латентно състояние и жизнените им процеси престават да функционират. Благодарение на това тези клетки, наречени спори, успяват да устоят на екстремни температури, налягане и дори на суровите условия на открития космос, пише Phys.org.
В определен момент (дори след множество години), когато условията отново станат подходящи, спорите могат да се събудят за броени минути и да се върнат към живот.
Спорите се събуждат, като се хидратират наново и рестартиат своя метаболизъм и физиология. Досега обаче учените нямаха представа дали те могат да държат под око средата, в която се намират, докато „спят“ (но без да се будят). В частност нямахме представа как спорите се справят с неясните сигнали за околната среда, които не индикират категорично, че условията са подходящи за живот. Дали в подобни ситуации спорите биха игнорирали тези „смесени условия“ или просто биха си взели бележка?
Ново изследване, проведено от биолози от Калифорнийския университет в Сан Диего и публикувано в Science, разплита тази мистерия. Според тях спорите на бактериите имат способността да оценяват обкръжаващата ги среда, докато пребивават във физиологична смърт. Te използват електрохимична енергия, която изпълнява ролята на кондензатор. Така спорите „решават“ дали условията за събуждане и продължаване на жизнения цикъл са благоприятни.
Много видове бактерии могат да прекарат хиляди години в спящ режим. Тази забележителна способност ги прави заплаха в случая на бактериалния антракс, както и в случаите на замърсяване на храна, в медицината и др.
Според изследването начинът, по който спорите достигат до информацията, е подобен на начина, по който оперират невроните в човешкия мозък. И при бактериите, и при невроните се получават периодични кратки сигнали, които дават информация за средата. Така спорите се връщат към живот. За разлика от невроните, които са зависими от енергията в организма, бактериите могат да получават тези сигнали без каквато и да било метаболитна енергия.
Изследването е публикувано в Science.